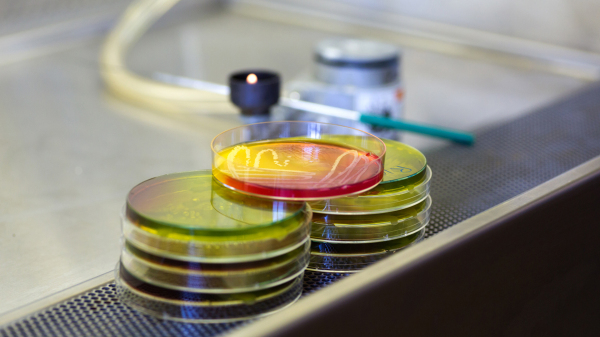
Foto von mehreren Petrischalen mit bunten Nährböden auf einem Labortisch

| Vor dem Studium — an der Fakultät für Chemie |

Fakultät für Chemie
Früher für Dich! Frühstudium für Schüler:innen
Du bist ein Chemie-Ass und ein:e extrem leistungsstarke und leistungsmotivierte Schüler:in?
Die UDE bietet dir die Chance bereits vor Erreichen ihres Abiturs qualifizierte Leistungsnachweise erwerben, die auf ein späteres Studium anrechenbar sind.

Fakultät für Chemie
Früher für Dich! Probestudiumfür Schüler:innen
Die Fakultät für Chemie bietet Schüler:innen der Jahrgangsstufen 10-13 regelmäßig die Möglichkeit an einem Probestudium teilzunehmen.
Du überlegst Chemie, Chemie Lehramt oder Water Science zu studieren?

Fakultät für Chemie
Früher für Dich! Sommer-Uni
(SUNI)
Die SUNI ist ein Angebot für Schüler*innen ab 15 Jahren und bietet ein spannendes Programm aus Vorlesungen, Übungen, Workshops und Laborexperimenten aus den Bereichen der Natur- und Ingenieurwissenschaften. Diese Vielfalt ermöglicht es den jungen Wissenschaftler*innen, ihre Interessen zu vertiefen und neue Perspektiven zu entdecken.

Fakultät für Chemie
Früher für Deinen Chemiekurs! SEPPSchüler-Experimentier-Praktikum
Ein komplett ausgestattetes Hochschullabor, in dem sämtliche Geräte vorhanden sind, ermöglicht den Schüler:innen Experimente selbstständig durchzuführen. Betreut wird das Praktikum von einem Team aus wissenschaftlichen Mitarbeitern, studentischen Hilfskräften und Berufsfeldpraktikanten der Didaktik der Chemie.
| Weitere Angebote zur Nachwuchsförderung |

Praktikumsangebote
- Praktikum zur Berufsfeldorientierung
- Girls-Day
- Betriebspraktikum (z. B. CTA)

Abiturtraining
Training für die Chemieolympiade

